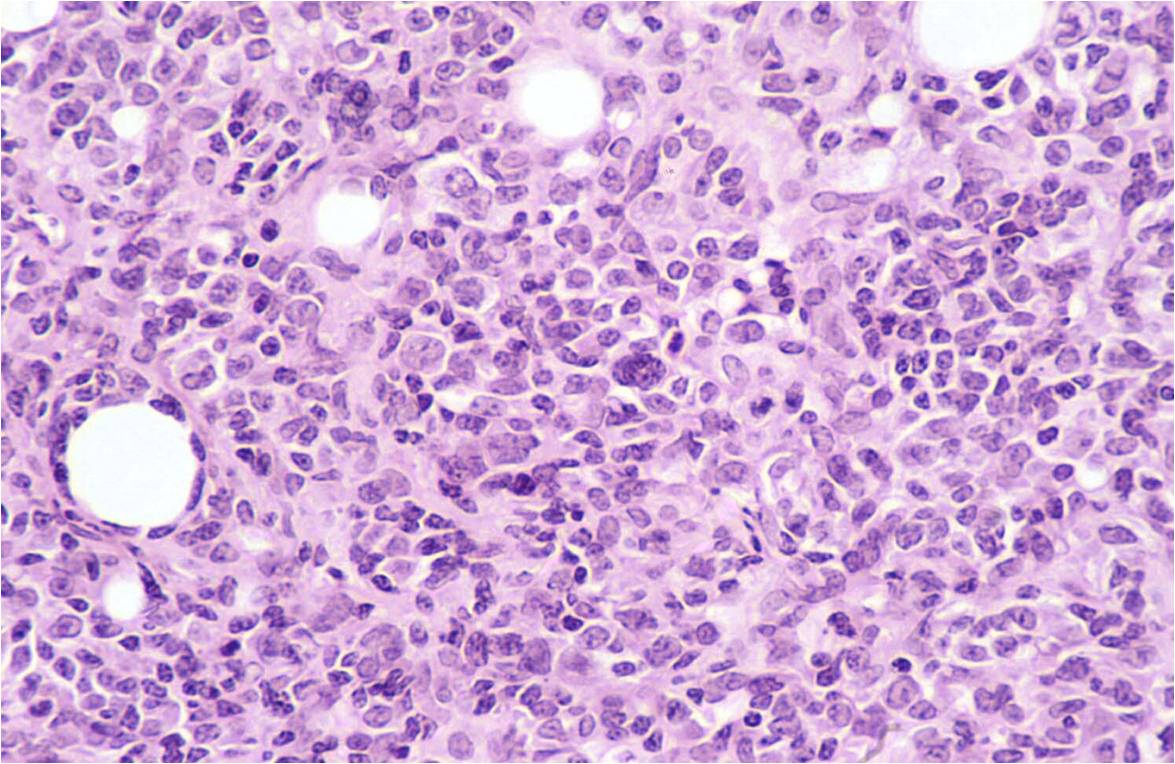

Figura 4

Figura 5

Figura 6
La demodicosis en el hámster casi siempre va asociada a una enfermedad subyacente. Se decidió realizar una biopsia de las placas indurativas ante la sospecha de que pudiera haber una neoplasia asociada. El resultado de la biopsia fue el siguiente: Presencia de ácaros del Gº Démodex en los folículos dilatados (Figura 4). Infiltrado en la dermis de células mononucleares (linfocitos y células plasmáticas). La tinción con CD4+ identifica a una población de linfocitos de carácter neoplásico (Figuras 5 y 6).

Figura 4 |

Figura 5 |
Figura 6 |
El diagnóstico definitivo es el de l infoma cutáneo T epiteliotropo asociado a demodicosis.